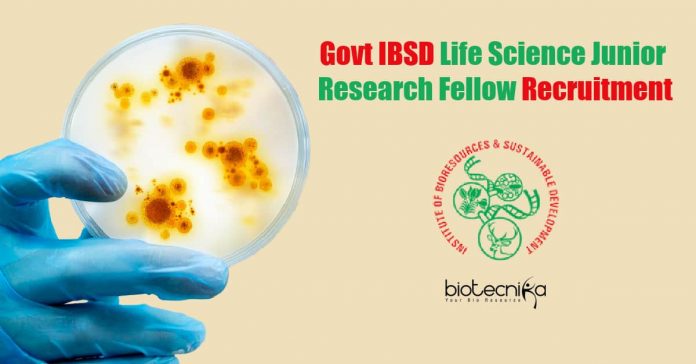

Govt IBSD Life Science Junior Research Fellow Recruitment
Govt IBSD Life Science Junior Research Fellow Recruitment. MSc/MTech Botany/Zoology/Life Sciences/Biotechnology candidates are encouraged to apply for Junior Research Fellow vacancy at Institute of Bioresources and Sustainable Development.
This Job Expires In :
ADVERTISEMENT NO. AP/140
Applications are invited from deserved and also suitable applicants for the post of Junior Research Fellow under the project entitled “Bioresources and Sustainable livelihoods in North East India” Component 3: Assess the economic value of bio-resources and their role in meeting the societal needs and sustainable development goals. Sub-project 1: Integrating the unique bioresources to enhance the ecotourism potential of the region.
Name of the Post: Junior Research Fellow
No. of Posts: 01
Upper Age Limit (years): 28
Duration: 2 months (likely to be extended up to Sep, 2021)
Duration of post: 2 months on contractual basis (likely to be extended up to Sep, 2021)
NoteThe above position is purely temporary and co- terminus with the project.
Application Process:
The selected candidate will not claim for a regular appointment either in IBSD, Imphal and also its centre/nodes or DBT, New Delhi. Recruitment of the above position shall be according to the Recruitment Rules of the Institute. Eligible and interested applicants may send their application with scan copies of the following documents via E-mail: [email protected] or [email protected] latest by 28th January 2021.
- A duly filled-in application which is given in the next page.
- Scanned copies of marks sheets, certifications, age evidence, Category (in case of SC/ST/OBC/ PWD applicants, relaxable for reserved categories as per GoI standards).
- Experience certificates, if any type of.
- List of publications/patents, if any kind of.
- In-depth biodata.
- Candidates need to provide their mobile no. and also Email.
Due to COVID-19 Pandemic situation, shortlisted candidates should appear interview through video conferencing as well as the details of which will be communicated through Email. No interim enquiries will certainly be entertained.
Consolidated monthly salary: Rs. 31,000/- +8% HRA For NET/GATE (as per DST OM. No.SR/S9/Z-08/2018 dated 30/01/2019.
Subject areas: Botany/Zoology/Life Sciences/Biotechnology/Environmental Science/ Ecology/ any other relevant discipline.
Essential Qualifications: M.Sc/M.Tech degree
Desirable Qualifications: NET/GATE Experience in Orchids cultivation and/or hybridization. For the development of new cultivars through hybridization. Should be
willing to travel extensively across the country with the main workplace being North-East India.
See Notification & Download Format From Below
Editor’s Note: Govt IBSD Life Science Junior Research Fellow Recruitment. Please make sure that you are subscribed to the Biotecnika Times Newsletter and our YouTube channel to be notified of all of the latest in the industry. Follow us on all of our social media like Twitter, Telegram, Facebook and Instagram.

Is microbiologist can also apply..??